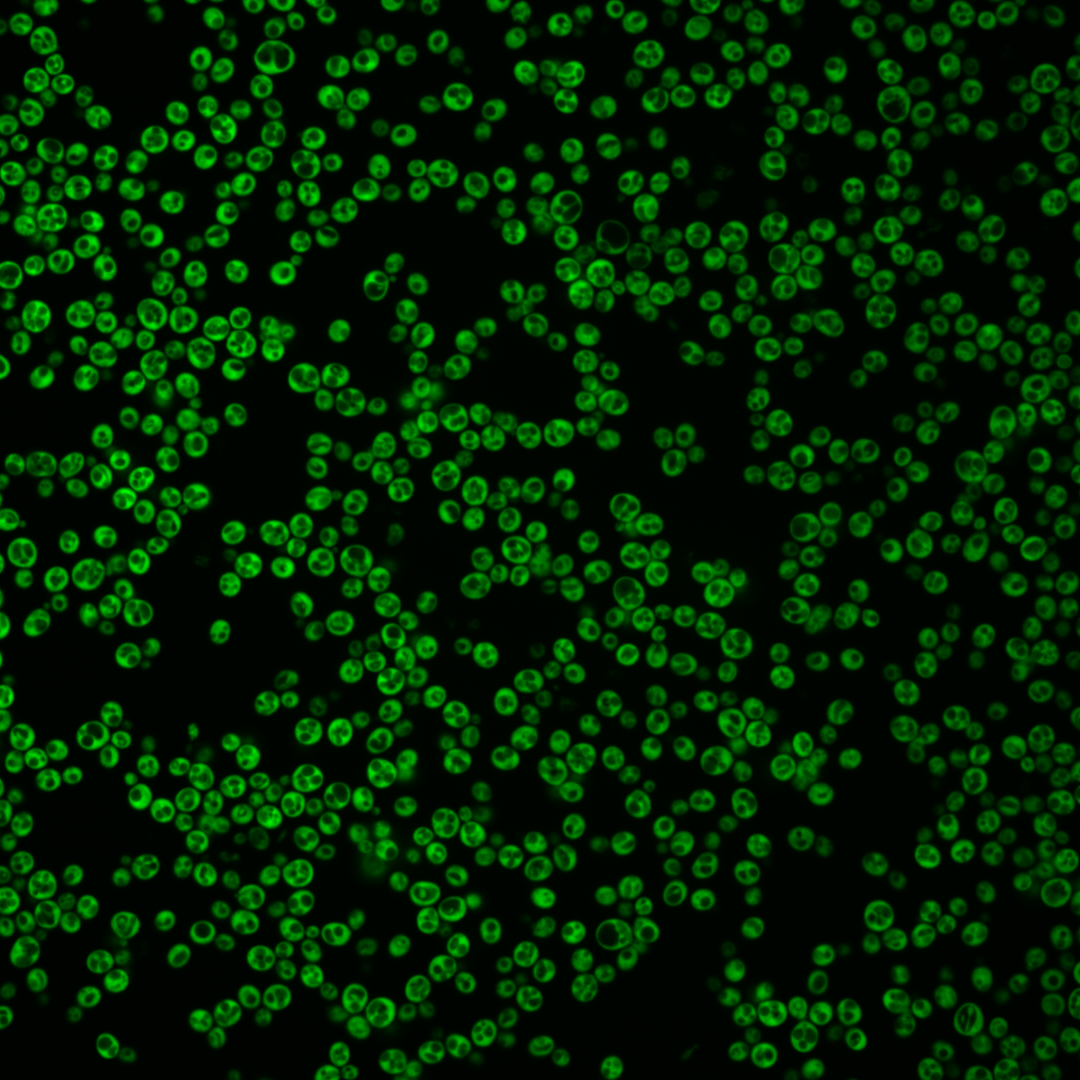
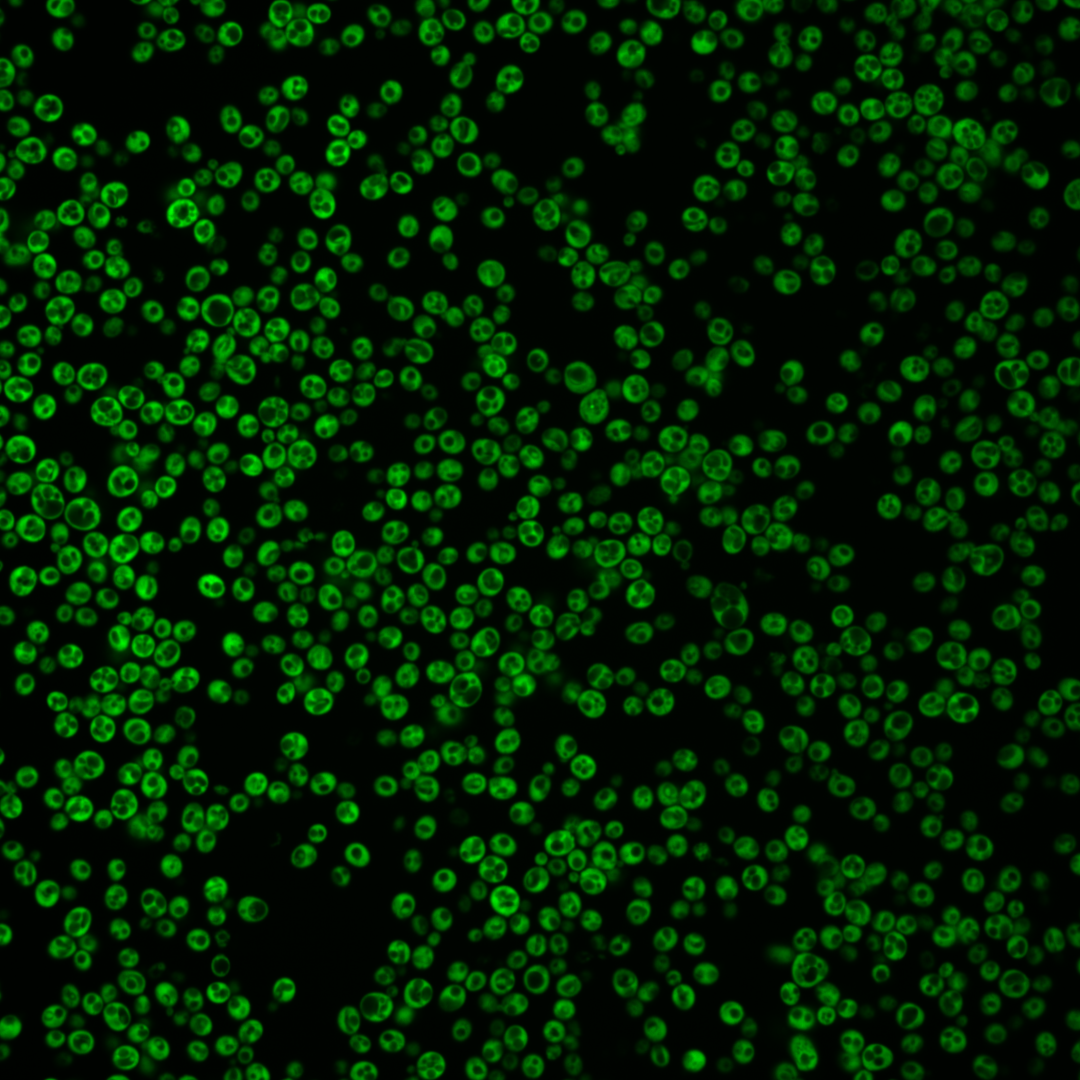
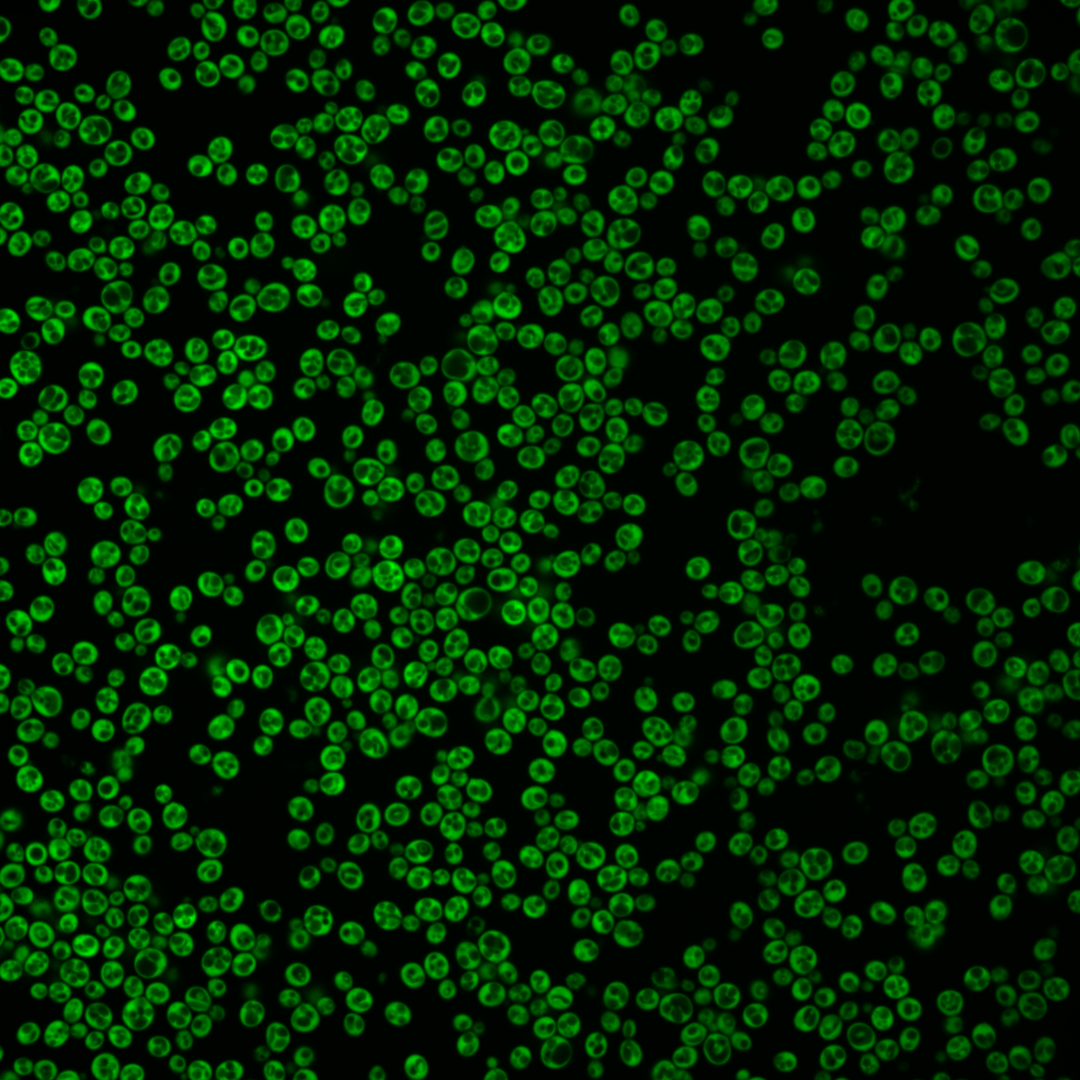
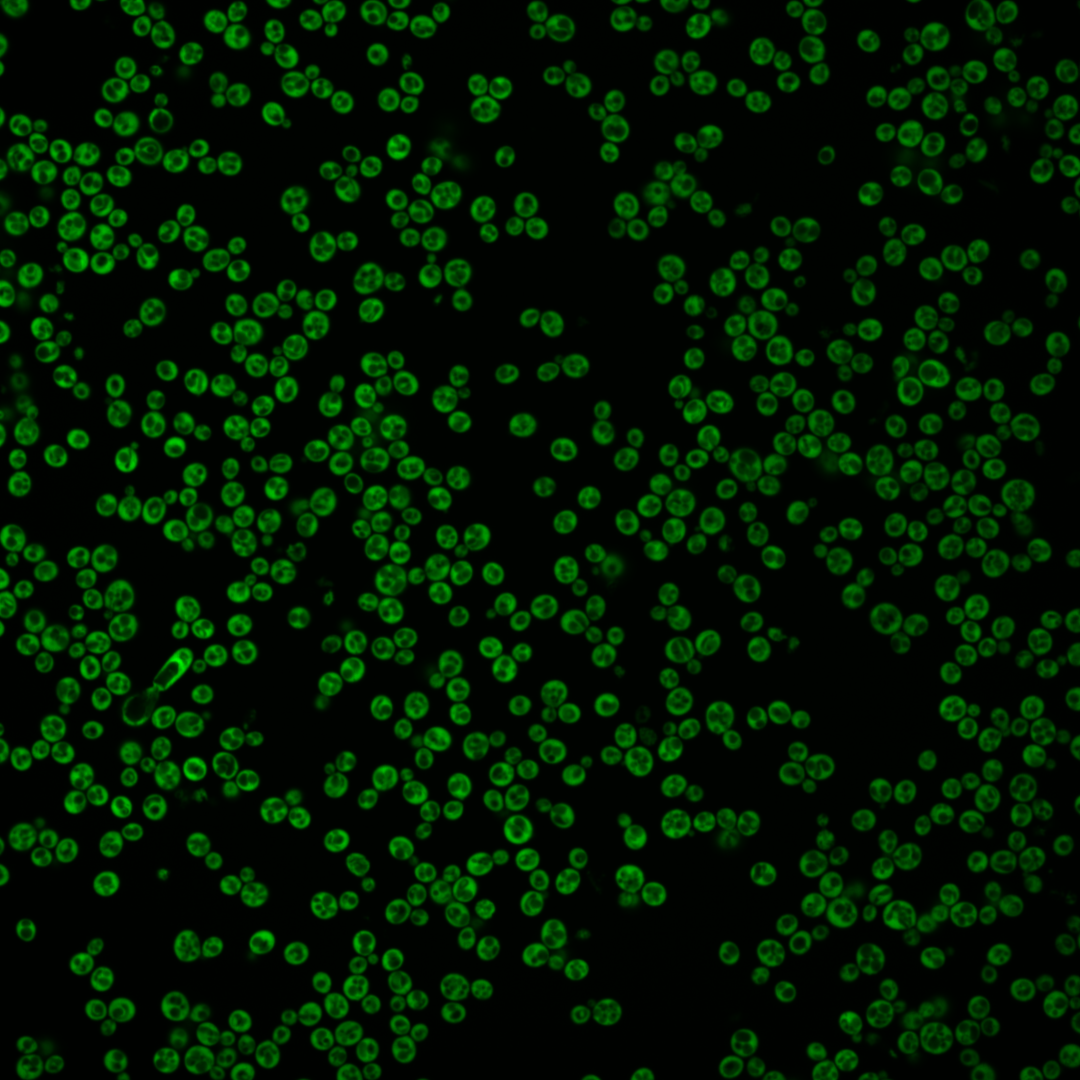
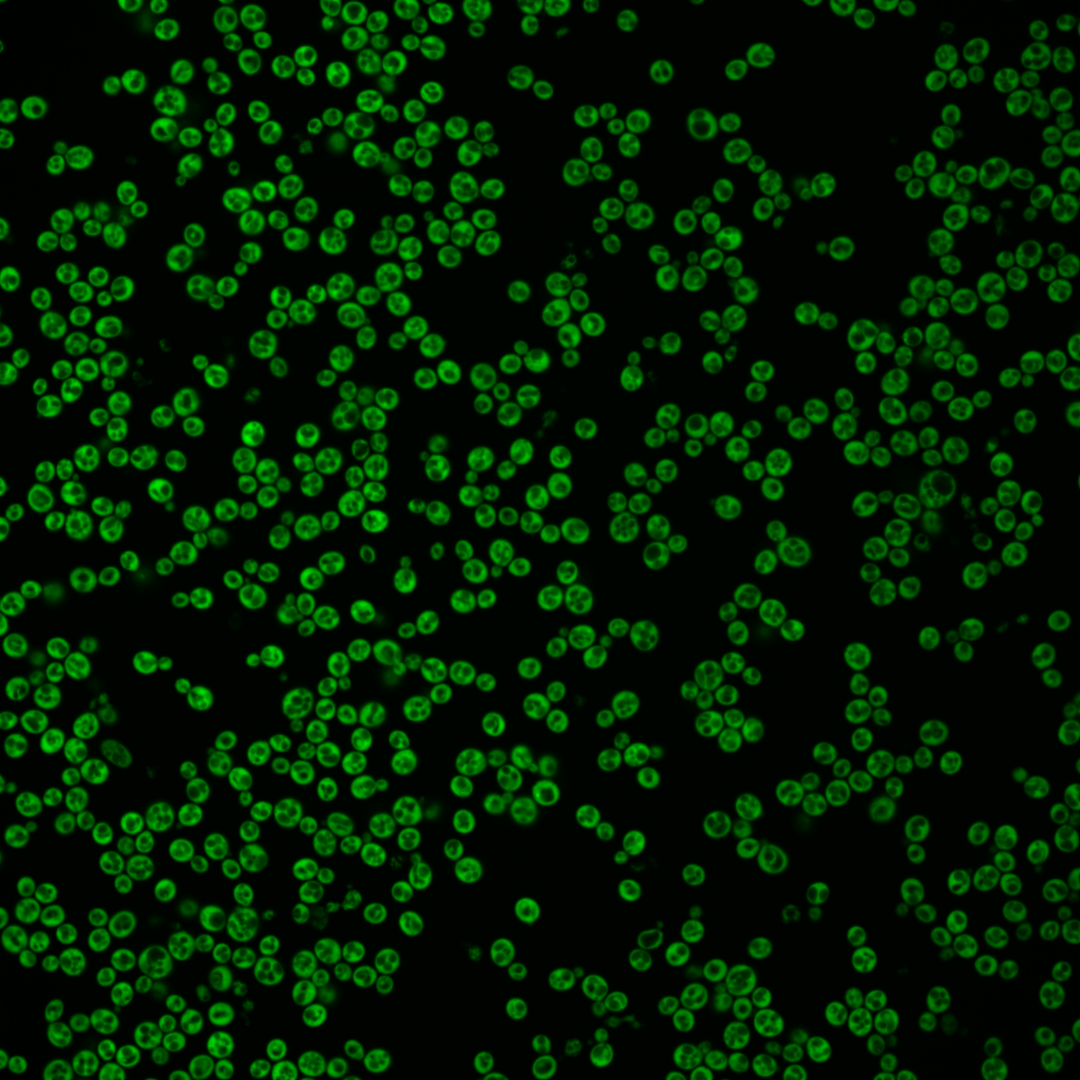

| Standard name | |
|---|---|
| Human Ortholog | |
| Description | Protein component of the small (40S) ribosomal subunit; homologous to mammalian ribosomal protein S4, no bacterial homolog; RPS4B has a paralog, RPS4A, that arose from the whole genome duplication |
Micrographs




















































































Sub-cellular Localization
Yeast GFP Assignment
Protein Abundance
Localization Change
External localization resources
| ensLOC | DeepLoc | |||||||||||||||||||||||
|---|---|---|---|---|---|---|---|---|---|---|---|---|---|---|---|---|---|---|---|---|---|---|---|---|
| Localization | WT1 | WT2 | WT3 | RAP60 | RAP140 | RAP220 | RAP300 | RAP380 | RAP460 | RAP540 | RAP620 | RAP700 | HU80 | HU120 | HU160 | rpd3Δ_1 | rpd3Δ_2 | rpd3Δ_3 | WT1 | WT2 | WT3 | AF100 | AF140 | AF180 |
| Cortical Patches | 0 | 0 | 0 | 0 | 0 | 1 | 2 | 5 | 9 | 9 | 4 | 8 | 0 | 0 | 0 | 0 | 0 | 0 | 0 | 0 | 0 | 0 | 0 | 0 |
| Bud | 0 | 1 | 0 | 0 | 0 | 0 | 0 | 0 | 0 | 0 | 1 | 0 | 0 | 1 | 0 | 0 | 0 | 0 | 0 | 1 | 1 | 0 | 1 | 1 |
| Bud Neck | 0 | 0 | 0 | 0 | 0 | 0 | 0 | 0 | 0 | 0 | 0 | 0 | 0 | 0 | 0 | 0 | 0 | 0 | 0 | 0 | 0 | 0 | 0 | 0 |
| Bud Site | 0 | 0 | 0 | 0 | 0 | 0 | 0 | 0 | 0 | 0 | 0 | 0 | 0 | 0 | 0 | 0 | 0 | 0 | – | – | – | – | – | – |
| Cell Periphery | 0 | 1 | 2 | 0 | 2 | 4 | 4 | 8 | 2 | 6 | 4 | 8 | 1 | 1 | 1 | 2 | 3 | 1 | 0 | 0 | 2 | 0 | 1 | 0 |
| Cytoplasm | 73 | 127 | 150 | 104 | 132 | 118 | 134 | 117 | 96 | 104 | 64 | 66 | 95 | 114 | 141 | 287 | 154 | 161 | 75 | 135 | 133 | 83 | 127 | 107 |
| Endoplasmic Reticulum | 0 | 0 | 0 | 0 | 3 | 6 | 19 | 23 | 16 | 17 | 7 | 10 | 2 | 0 | 0 | 17 | 14 | 10 | 0 | 0 | 5 | 3 | 5 | 8 |
| Endosome | 0 | 0 | 0 | 0 | 0 | 0 | 0 | 0 | 0 | 0 | 0 | 0 | 0 | 0 | 0 | 0 | 1 | 0 | 0 | 0 | 0 | 0 | 0 | 0 |
| Golgi | 0 | 0 | 0 | 0 | 0 | 0 | 0 | 4 | 3 | 3 | 0 | 1 | 0 | 0 | 0 | 0 | 0 | 0 | 0 | 0 | 0 | 0 | 0 | 0 |
| Mitochondria | 0 | 0 | 0 | 0 | 0 | 0 | 0 | 1 | 3 | 5 | 9 | 1 | 0 | 0 | 0 | 0 | 0 | 0 | 0 | 0 | 0 | 0 | 0 | 0 |
| Nucleus | 0 | 0 | 0 | 0 | 0 | 1 | 0 | 1 | 0 | 1 | 0 | 0 | 0 | 0 | 0 | 1 | 2 | 0 | 0 | 0 | 0 | 0 | 0 | 0 |
| Nuclear Periphery | 0 | 0 | 0 | 0 | 0 | 0 | 0 | 0 | 0 | 0 | 0 | 0 | 0 | 0 | 0 | 0 | 0 | 0 | 0 | 0 | 0 | 0 | 0 | 0 |
| Nucleolus | 0 | 0 | 0 | 0 | 0 | 0 | 0 | 0 | 0 | 0 | 1 | 0 | 0 | 0 | 0 | 0 | 1 | 1 | 0 | 0 | 0 | 0 | 0 | 0 |
| Peroxisomes | 0 | 0 | 0 | 0 | 0 | 0 | 0 | 0 | 0 | 0 | 0 | 0 | 0 | 0 | 0 | 0 | 0 | 0 | 0 | 0 | 0 | 0 | 0 | 0 |
| SpindlePole | 0 | 0 | 0 | 0 | 0 | 0 | 0 | 0 | 0 | 0 | 0 | 0 | 0 | 0 | 0 | 0 | 0 | 0 | 0 | 0 | 0 | 0 | 0 | 0 |
| Vac/Vac Membrane | 0 | 0 | 0 | 2 | 0 | 0 | 0 | 0 | 0 | 0 | 2 | 0 | 1 | 0 | 0 | 1 | 3 | 1 | 0 | 2 | 0 | 0 | 4 | 0 |
| Unique Cell Count | 73 | 127 | 151 | 106 | 137 | 126 | 159 | 149 | 119 | 133 | 81 | 87 | 98 | 115 | 141 | 291 | 162 | 163 | 78 | 144 | 151 | 92 | 145 | 122 |
| Labelled Cell Count | 73 | 129 | 152 | 106 | 137 | 130 | 159 | 159 | 129 | 145 | 92 | 94 | 99 | 116 | 142 | 308 | 178 | 174 | 78 | 144 | 151 | 92 | 145 | 122 |
Yeast GFP Assignment
Protein Abundance
| Screen | WT1 | WT2 | WT3 | RAP60 | RAP140 | RAP220 | RAP300 | RAP380 | RAP460 | RAP540 | RAP620 | RAP700 | HU80 | HU120 | HU160 | rpd3Δ_1 | rpd3Δ_2 | rpd3Δ_3 | AF100 | AF140 | AF180 |
|---|---|---|---|---|---|---|---|---|---|---|---|---|---|---|---|---|---|---|---|---|---|
| Mean Cell GFP Intensity (1e-4) | 132.5 | 169.9 | 124.1 | 122.8 | 97.1 | 74.2 | 61.3 | 58.9 | 54.3 | 53.1 | 42.8 | 52.4 | 134.1 | 135.1 | 135.6 | 265.5 | 250.5 | 252.2 | 135.3 | 140.3 | 156.3 |
| Std Deviation (1e-4) | 24.4 | 33.0 | 29.8 | 32.1 | 23.5 | 18.3 | 19.7 | 16.4 | 14.5 | 14.7 | 12.7 | 15.5 | 35.3 | 34.0 | 36.1 | 66.6 | 92.8 | 75.9 | 31.8 | 44.0 | 51.6 |
| Intensity Change (Log2) | – | – | – | -0.02 | -0.35 | -0.74 | -1.02 | -1.08 | -1.19 | -1.22 | -1.53 | -1.24 | 0.11 | 0.12 | 0.13 | 1.1 | 1.01 | 1.02 | 0.12 | 0.18 | 0.33 |
Localization Change
| Localization | RAP60 | RAP140 | RAP220 | RAP300 | RAP380 | RAP460 | RAP540 | RAP620 | RAP700 | HU80 | HU120 | HU160 | rpd3Δ_1 | rpd3Δ_2 | rpd3Δ_3 |
|---|---|---|---|---|---|---|---|---|---|---|---|---|---|---|---|
| Cortical Patches | 0 | 0 | 0 | 0 | 0 | 0 | 0 | 0 | 0 | 0 | 0 | 0 | 0 | 0 | 0 |
| Bud | 0 | 0 | 0 | 0 | 0 | 0 | 0 | 0 | 0 | 0 | 0 | 0 | 0 | 0 | 0 |
| Bud Neck | 0 | 0 | 0 | 0 | 0 | 0 | 0 | 0 | 0 | 0 | 0 | 0 | 0 | 0 | 0 |
| Bud Site | 0 | 0 | 0 | 0 | 0 | 0 | 0 | 0 | 0 | 0 | 0 | 0 | 0 | 0 | 0 |
| Cell Periphery | 0 | 0 | 0 | 0 | 0 | 0 | 0 | 0 | 0 | 0 | 0 | 0 | 0 | 0 | 0 |
| Cytoplasm | -0.9 | -1.8 | -2.7 | -4.8 | -5.8 | -5.4 | -5.8 | -5.5 | -6.0 | -1.5 | -0.2 | 1.0 | -0.7 | -2.3 | -0.5 |
| Endoplasmic Reticulum | 0 | 0 | 0 | 4.4 | 5.0 | 4.6 | 4.5 | 0 | 0 | 0 | 0 | 0 | 3.0 | 3.7 | 0 |
| Endosome | 0 | 0 | 0 | 0 | 0 | 0 | 0 | 0 | 0 | 0 | 0 | 0 | 0 | 0 | 0 |
| Golgi | 0 | 0 | 0 | 0 | 0 | 0 | 0 | 0 | 0 | 0 | 0 | 0 | 0 | 0 | 0 |
| Mitochondria | 0 | 0 | 0 | 0 | 0 | 0 | 0 | 0 | 0 | 0 | 0 | 0 | 0 | 0 | 0 |
| Nucleus | 0 | 0 | 0 | 0 | 0 | 0 | 0 | 0 | 0 | 0 | 0 | 0 | 0 | 0 | 0 |
| Nuclear Periphery | 0 | 0 | 0 | 0 | 0 | 0 | 0 | 0 | 0 | 0 | 0 | 0 | 0 | 0 | 0 |
| Nucleolus | 0 | 0 | 0 | 0 | 0 | 0 | 0 | 0 | 0 | 0 | 0 | 0 | 0 | 0 | 0 |
| Peroxisomes | 0 | 0 | 0 | 0 | 0 | 0 | 0 | 0 | 0 | 0 | 0 | 0 | 0 | 0 | 0 |
| SpindlePole | 0 | 0 | 0 | 0 | 0 | 0 | 0 | 0 | 0 | 0 | 0 | 0 | 0 | 0 | 0 |
| Vacuole | 0 | 0 | 0 | 0 | 0 | 0 | 0 | 0 | 0 | 0 | 0 | 0 | 0 | 0 | 0 |
External localization resources
Images






























Protein Concentration and Protein Localization Data
| R1 | R2 | R3 | ||||||||||||||||
|---|---|---|---|---|---|---|---|---|---|---|---|---|---|---|---|---|---|---|
| G1 Pre-START | G1 Post-START | S/G2 | Metaphase | Anaphase | Telophase | G1 Pre-START | G1 Post-START | S/G2 | Metaphase | Anaphase | Telophase | G1 Pre-START | G1 Post-START | S/G2 | Metaphase | Anaphase | Telophase | |
| Concentration | 150.6706 | 204.6316 | 182.9845 | 167.6963 | 156.0514 | 127.3431 | 143.6659 | 203.9692 | 174.9257 | 151.5311 | 142.5723 | 134.4407 | 103.434 | 177.9097 | 161.4986 | 207.4217 | 118.5159 | 156.5716 |
| Actin | 0.0034 | 0.0013 | 0.0017 | 0.0049 | 0.0008 | 0.0018 | 0.0154 | 0.0004 | 0.0019 | 0.0014 | 0.001 | 0.0024 | 0.034 | 0.032 | 0.0181 | 0.0021 | 0.0053 | 0.0137 |
| Bud | 0.0046 | 0.0034 | 0.0034 | 0.0068 | 0.0032 | 0.0084 | 0.0031 | 0.0015 | 0.004 | 0.0023 | 0.0032 | 0.0013 | 0.0059 | 0.002 | 0.0088 | 0.0043 | 0.0126 | 0.0187 |
| Bud Neck | 0.0012 | 0.0009 | 0.0014 | 0.0017 | 0.0012 | 0.0024 | 0.0025 | 0.0011 | 0.0026 | 0.0014 | 0.0034 | 0.0078 | 0.0012 | 0.0014 | 0.0012 | 0.0029 | 0.0011 | 0.0056 |
| Bud Periphery | 0.0063 | 0.0023 | 0.0029 | 0.0088 | 0.0024 | 0.0038 | 0.0088 | 0.0015 | 0.0064 | 0.002 | 0.0019 | 0.0009 | 0.0067 | 0.0013 | 0.0082 | 0.0059 | 0.0221 | 0.0373 |
| Bud Site | 0.002 | 0.0023 | 0.0018 | 0.0017 | 0.0009 | 0.0012 | 0.0041 | 0.0093 | 0.0024 | 0.0007 | 0.0012 | 0.0004 | 0.0032 | 0.0018 | 0.0049 | 0.0018 | 0.0023 | 0.0044 |
| Cell Periphery | 0.0722 | 0.0608 | 0.0833 | 0.0734 | 0.0129 | 0.008 | 0.1194 | 0.0686 | 0.1016 | 0.0703 | 0.0141 | 0.0313 | 0.032 | 0.0384 | 0.0208 | 0.151 | 0.0455 | 0.0523 |
| Cytoplasm | 0.487 | 0.6792 | 0.5032 | 0.2577 | 0.3784 | 0.4963 | 0.349 | 0.693 | 0.5939 | 0.3767 | 0.4425 | 0.6179 | 0.3009 | 0.6926 | 0.5881 | 0.2565 | 0.1637 | 0.3026 |
| Cytoplasmic Foci | 0.018 | 0.0015 | 0.0024 | 0.0018 | 0.0235 | 0.0025 | 0.0185 | 0.0007 | 0.0136 | 0.0045 | 0.0533 | 0.0026 | 0.0208 | 0.0187 | 0.0052 | 0.001 | 0.004 | 0.0028 |
| Eisosomes | 0.0004 | 0.0001 | 0.0001 | 0.0003 | 0.001 | 0 | 0.0015 | 0 | 0.0003 | 0.0023 | 0.0002 | 0 | 0.001 | 0.0007 | 0.0009 | 0.0027 | 0.0002 | 0.0039 |
| Endoplasmic Reticulum | 0.028 | 0.0046 | 0.014 | 0.0066 | 0.0058 | 0.0137 | 0.0285 | 0.0065 | 0.0099 | 0.0043 | 0.0067 | 0.0376 | 0.0575 | 0.0044 | 0.0088 | 0.0027 | 0.014 | 0.0088 |
| Endosome | 0.0094 | 0.0037 | 0.0093 | 0.0084 | 0.0299 | 0.0325 | 0.0132 | 0.0016 | 0.0073 | 0.0055 | 0.0677 | 0.0168 | 0.0169 | 0.0036 | 0.0178 | 0.0019 | 0.0413 | 0.0068 |
| Golgi | 0.002 | 0.0007 | 0.0013 | 0.0012 | 0.0017 | 0.0009 | 0.0029 | 0.0002 | 0.0011 | 0.0007 | 0.0104 | 0.0018 | 0.0051 | 0.002 | 0.0058 | 0.0006 | 0.0078 | 0.0015 |
| Lipid Particles | 0.0046 | 0.002 | 0.0026 | 0.0028 | 0.0067 | 0.0006 | 0.0091 | 0.002 | 0.0075 | 0.0066 | 0.0069 | 0.0064 | 0.0089 | 0.0042 | 0.003 | 0.006 | 0.0038 | 0.0054 |
| Mitochondria | 0.0128 | 0.0029 | 0.0036 | 0.0036 | 0.0219 | 0.0042 | 0.0161 | 0.0005 | 0.0084 | 0.0338 | 0.0102 | 0.002 | 0.0156 | 0.0037 | 0.0355 | 0.0062 | 0.1542 | 0.0789 |
| None | 0.0066 | 0.0006 | 0.001 | 0.0011 | 0.0097 | 0.0016 | 0.0076 | 0.0003 | 0.0059 | 0.0058 | 0.0066 | 0.0009 | 0.0094 | 0.0013 | 0.0216 | 0.0016 | 0.0032 | 0.0063 |
| Nuclear Periphery | 0.0338 | 0.0068 | 0.0114 | 0.0127 | 0.022 | 0.1575 | 0.0432 | 0.0062 | 0.0086 | 0.0208 | 0.0577 | 0.0874 | 0.0953 | 0.0185 | 0.0191 | 0.0285 | 0.0279 | 0.0383 |
| Nucleolus | 0.0052 | 0.0015 | 0.0028 | 0.0041 | 0.0248 | 0.0011 | 0.0103 | 0.0012 | 0.0133 | 0.0143 | 0.0162 | 0.001 | 0.0108 | 0.002 | 0.0099 | 0.0872 | 0.046 | 0.025 |
| Nucleus | 0.0179 | 0.0067 | 0.0105 | 0.0187 | 0.0143 | 0.0845 | 0.0168 | 0.0055 | 0.0119 | 0.0142 | 0.0122 | 0.0566 | 0.1315 | 0.0186 | 0.0141 | 0.0433 | 0.0865 | 0.1404 |
| Peroxisomes | 0.0005 | 0.0002 | 0.0002 | 0.0002 | 0.0016 | 0.0004 | 0.0015 | 0.0001 | 0.0007 | 0.0016 | 0.0016 | 0.0002 | 0.0012 | 0.0058 | 0.0014 | 0.0006 | 0.0006 | 0.002 |
| Punctate Nuclear | 0.0023 | 0 | 0.0003 | 0.0008 | 0.0003 | 0.0015 | 0.0017 | 0 | 0.002 | 0.0002 | 0.0011 | 0.0012 | 0.058 | 0.0429 | 0.0003 | 0.0001 | 0.0003 | 0.0006 |
| Vacuole | 0.2206 | 0.1877 | 0.2796 | 0.4301 | 0.3049 | 0.1252 | 0.2861 | 0.1853 | 0.1758 | 0.3446 | 0.2063 | 0.1034 | 0.1315 | 0.088 | 0.1318 | 0.288 | 0.2136 | 0.1432 |
| Vacuole Periphery | 0.0613 | 0.031 | 0.0632 | 0.1524 | 0.1321 | 0.0522 | 0.0406 | 0.0146 | 0.0207 | 0.0862 | 0.0753 | 0.0198 | 0.0526 | 0.0163 | 0.0748 | 0.1049 | 0.1441 | 0.1015 |
Sequencing Data
| R1 | R2 | |||||||||
|---|---|---|---|---|---|---|---|---|---|---|
| G1 Post-START | S/G2 | Metaphase | Anaphase | Telophase | G1 Post-START | S/G2 | Metaphase | Anaphase | Telophase | |
| Gene Expression | 3103.1495 | 2888.8524 | 3110.2525 | 3335.7128 | 3354.4759 | 2250.4846 | 2849.5423 | 2656.9654 | 2678.1639 | 2895.0607 |
| Translational Efficiency | 0.8168 | 0.8782 | 0.9055 | 0.6259 | 0.8752 | 1.1078 | 0.8811 | 0.8596 | 0.8853 | 0.9393 |
Hit Data
| Dataset | Hit |
|---|---|
| Protein Concentration | ✔ |
| Protein Localization | ✘ |
| Gene Expression | ✘ |
| Translational Efficiency | ✘ |
Endocytosis
| Temp | Actin Patch (Sac6-tdTomato) | Cortical Patch (Sla1-GFP) | Late Endosome (Snf7-GFP) | Vacuole (Vph1-GFP) |
|---|---|---|---|---|
| 37℃ | ||||
| RT |
Cell Cycle Omics
CYCLoPs (Rps4b-GFP)
| Gene / Allele | Actin Patch (Sac6-tdTomato) | Cortical Patch (Sla1-GFP) | Late Endosome (Snf7-GFP) | Vacuole (Sac6-tdTomato) |
|---|
| Gene | Images |
|---|
| Gene | Images |
|---|
Images are not yet available
Images are not yet available